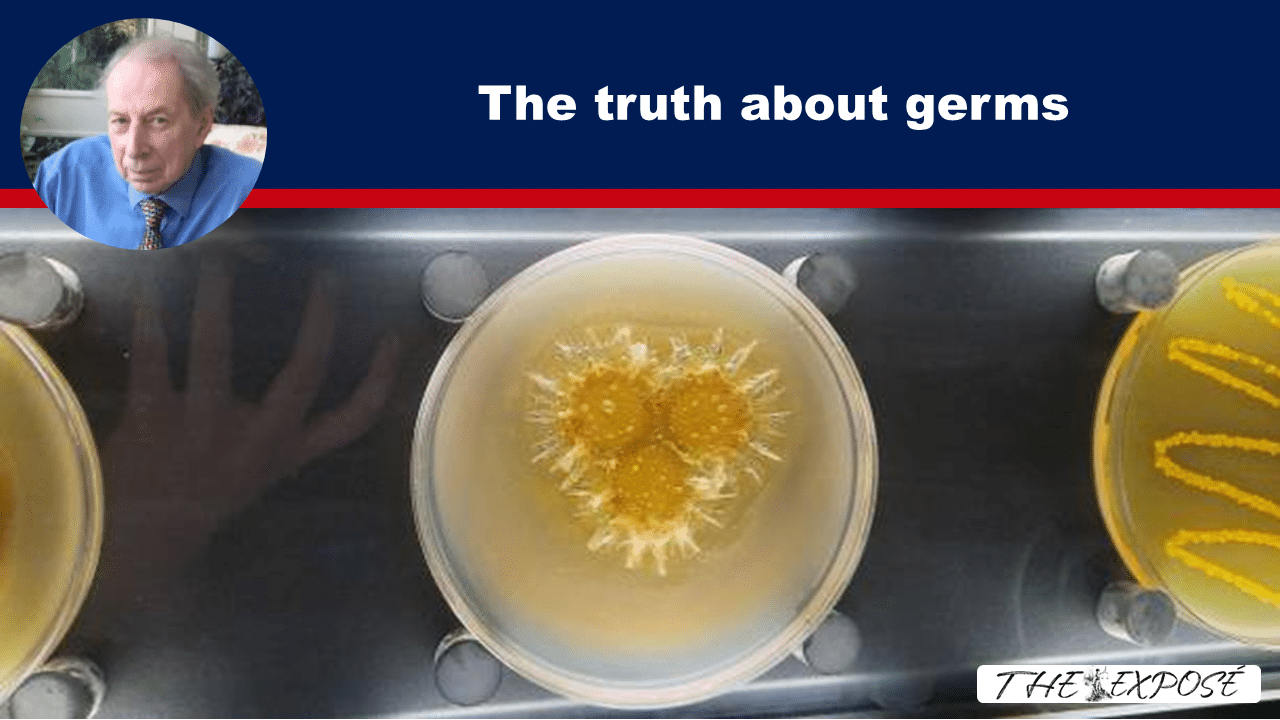
- The Expose

For those who believe germs don’t exist, Dr. Vernon Coleman sets the record straight.
The notion that germs do not exist is a form of manipulation used by psy-op specialists, including the CIA, to spread confusion and nonsense.
This myth is promoted by a small but loud group of people who are often ignorant and untrained in medical or scientific fields, and who use abuse and intimidation to silence critics.
Let’s not lose touch…Your Government and Big Tech are actively trying to censor the information reported by The Exposé to serve their own needs. Subscribe to our emails now to make sure you receive the latest uncensored news in your inbox…
The most popular modern form of manipulation is to recruit the ignorant and ill-informed and use them to help spread damaging and confusing nonsense. And that is exactly what is behind the absurd notion that germs do not exist.
Vladislav Surkov, a Kremlin communications expert and advisor to Putin, was one of the originators of this manipulative trickery, and psyop specialists everywhere now use Surkov’s techniques. The CIA uses the same technique.
The basic aim is to trick truth-tellers (invariably described as conspiracy theorists) into arguing with one another about side issues, while the real agenda plays out unnoticed. This technique has had a huge impact on all our lives and has given confused and confusing voices to bigoted and prejudiced trolls.
So, for example, there are the claims that the Earth is flat, that fossil fuels don’t exist (a lie to detract from the truth which is that fossil fuels are running out – this is the main reason why they don’t want us to travel), that there is no such thing as cancer, that the very existence of nuclear power is a myth, that there are unending supplies of oil hidden away and so on and so on. There are, of course, a number of other things that the naïve, the ignorant and the misinformed people say without worrying about finding any evidence for their claims. They say that eating hormone and drug-soaked meat is good for you and (rather surprisingly, perhaps) they agree with the CIA that covid originated in a laboratory in Wuhan, China, though the statistical evidence proves conclusively that it was simply the remarketed and weaponised standard annual flu. (The CIA want us to believe that covid originated in a laboratory so that we will accept it is a dangerous, killer infection and NOT the flu. If they can convince us it was made in a laboratory, they can excuse the lockdowns and so on.)
But the most absurd and dangerous myth comes from the relatively small but exceedingly noisy group of individuals who claim (with all the wild fervour of cultists everywhere) that germs do not exist.
One common but naïve and indefensible statement is that “infectious microbes of any kind do not exist.” There is a subset cult whose members believe that viruses don’t exist, but most simply claim that there are no germs. (I do suspect that some of those who advocate this nonsense are so ignorant that they think that the words “germ” and “virus” are synonymous.)
This absurd claim has created massive confusion, making truth-tellers as a whole a laughing stock among doctors, scientists and intelligent people. (The statement that “The anti-vaxxers don’t even believe that germs exist!” is repeated with a sly chuckle and a knowing nodding of heads. I have not met one licensed physician or surgeon who believes in this nonsense. Not one. I suspect that many of those talking most aggressively and promoting the “there are no germs” theory with the greatest certainty have nothing more relevant than a Certificate in Fallen Leaf Management or a Diploma in Simulated Brass Rubbing.)
And that’s the point, isn’t it? The undeniable truth is that the vast majority of those promoting the idea that germs do not exist have little or no relevant medical or scientific training whatsoever. Some seem to think that their ignorance gives them a special right to lead the discussion. It never occurs to them that they are being used as pawns in a much bigger game. They have never heard of Surkov.
You can always tell a nasty cult by the fact that instead of providing evidence, the believers merely abuse those who dare to question their beliefs. (You’d think they’d aim their abuse at supporters of the medical establishment but curiously they don’t – preferring to target those who question the medical establishment and the drug industry. I’ve been the recipient of more than enough venom from these cultists. Two threatened to kill me and one tried to “bribe” me to say publicly that germs don’t exist. (I have the email proof). I can only assume they want to discredit me and use me to help drag more innocents into the cult.)
The result of the abuse is that very few people dare criticise those who believe that germs don’t exist. But after a lifetime of attacks, censorship, lies, libels and abuse from drug companies and government agencies, I don’t have much to lose.
Some of the most vocal, arrogant and persistent trolls who now inhabit and dominate this peculiar branch of the internet hinterland have built a pseudoscience on half-truths and misinterpretations. Some of the most vocal somehow manage to be ignorant and patronising at the same time. They have already done unprecedented amounts of damage. These cultists are not members of a harmless and slightly dotty group. They are dangerous and will take us through the horrors of net zero and into the Great Reset and a world dominated by compulsory, mass vaccinations.
These cultists are quite entitled not to believe in germs (though I wouldn’t like to eat a salad they’d prepared), but why be so dogmatic?
They have destroyed the credibility of those of us questioning the medical establishment and have done more damage to mankind than anyone else. Without their peculiar brand of pseudoscience, we could by now have destroyed the pharma-medical alliance and the vaccine industry.
“I don’t mind if you don’t believe in germs,” I said to one patronising non-believer. “Just let me believe in them. I believe in the work of Snow, Semmelweiss, Lister and the inbuilt wisdom of the body.”
I have studied, and respect, the work of Fracastorius, Leeuwenhoek, Chadwick and Sir William Petty, among many others, but I very much doubt if this indignant cultist had even heard of these people or their work.
“No!” he screamed in childlike rage. “You must agree with ME.”
A man who claimed to be a publisher offered to publish a number of my books in his language but made it clear that he would only do this if I would publicly state that germs don’t exist. Naturally, his crude attempt at bribery failed. I assume the plan was to discredit me. I don’t know who was behind the attempted bribe. It could have been the CIA, but I rather favour the drug industry – it’s the sort of thing drug companies would do.
I wonder if he’d still not believe in germs if he saw a child screaming with otitis media or an old man dying of a chest infection, which could be relieved in hours and cured in days with an appropriate antibiotic.
I wonder how these cultists explain the epidemic of sepsis now resulting from the deliberate failure of doctors to prescribe antibiotics when they are required. (Doctors have been told to reduce the prescribing of antibiotics because the use of drugs causes global warming. There is, of course, not one shred of evidence to support this very dangerous nonsense which has caused the incidence of sepsis – and sepsis deaths – to rocket.)
I wonder if the cultists who don’t believe in germs would like to be operated on by a surgeon who sharpened his knife on the sole of his boot. (That’s what surgeons used to do before germs were discovered. The patients usually died.)
The members of this cult dismiss epidemiology as if it were as unscientific as astrology. But you can’t glibly dismiss epidemiology any more than you can ignore the existence of the elephant.
Nor can you dismiss the existence of the immune system. To say there is no such thing as an immune system is as absurd as claiming that there is no such thing as a spine. The people dismissing these fundamental building blocks of medical science are as ignorant as they are arrogant, and they are doing an unbelievable amount of harm.
The freedom to explore new ideas and to share them and debate them is great if you’re prepared to put in the work required to learn something first. Sadly, too many people are keen to share views which are based on nothing but prejudice and myth.
The odd thing is that the devotees of the theory that germs do not exist (most of whom have never removed an appendix let alone a stitch and who couldn’t tell you the difference between a cerebrum and a cerebellum) attack me viciously (clearly determined to silence my campaigning against the medical establishment and the drug industry) but I’ve never seen them attack establishment doctors, chiropractors, osteopaths and others who appear on corporate media and YouTube. Instead, they follow me around like cowardly, rabid, snappy farm dogs. I have been the biggest critic of the pharmaceutical industry for five decades but they are clearly determined to silence me in any way they can. In the distant days when I could make videos and was allowed to do interviews, they never wanted to debate their views. They merely bullied and sneered.
I long ago lost count of the number of physical threats made by individuals (usually anonymous) who claim that there are no germs and that, in order to prove that claim, they will beat me up.
I can understand this enthusiasm to throw out every piece of traditional science and to assume that all medical science must be a lie. I’ve been pretty close to that on many occasions over the last fifty to sixty years of writing about medicine. There is no doubt that the medical establishment was long ago bought by the pharmaceutical industry.
Most of the “no germ” cultists are enthusiastic bloggers, are still interviewed on mainstream media and, most astonishing of all, still have channels on YouTube (which long ago threw off those who question the establishment view). They are also allowed free access to social media. (I am banned from accessing YouTube or social media because of my attacks on the establishment.)
The celebrity world of social media has created and given voices to vast armies of people who have no medical or scientific training and no real understanding of the many subjects on which they claim to be experts, but who freely make absurd statements and viciously attack anyone whose views (based on learning and understanding) they find objectionable. They never enter into debate because they know that their ignorance will be exposed if they do. I believe that they are manipulated by the security services who have good reason to support the cult and who know that the war against the conspiracy can most easily be destroyed by the exaggerated enthusiasm of those who are members of cults such as this and who can be manipulated into attacking the genuine truth-tellers.
The claims of many of these individuals are usually devoid of any attempt to offer a solid, scientific explanation for their ideas. Most have never treated an infection, struggled to find an appropriate antibiotic or dealt with a real epidemic. None seems to realise that the germs they claim don’t exist have been seen and examined. Even viruses can be viewed under an electron microscope. (I’ve seen them.) And yet they suddenly know enough to be patronising and superior. For example, one enthusiast claimed that headaches are not infectious and so why should we believe that chickenpox, measles or the flu might be transmitted by infection? The obvious point that measles, etc., spread quickly from person to person, suggesting some element of communicability, whereas headaches are solitary diseases, is lost on them. The flu will spread through a family, an office or a school, but headaches do not. I have never heard of mothers organising headache parties so that their children will all get their headaches over and done with.
One of the commonest illnesses requiring a GP to visit at night is a childhood ear infection. I used to carry starter doses of antibiotics in my black bag so that I could give parents medication immediately. The crying child would be asleep and half-way better before I got home.
Those parents who have been convinced that germs do not exist are now confused and won’t take their child to the hospital. (In the UK, GPs work part-time and no longer visit patients at home.)
The idea that there are no germs is promoted by those who wish to discredit the real truth-tellers and to encourage the simple-minded (who will believe just about anything they are offered as long as it is critical and sounds exotic). They have built a half theory on a half-baked hypotheses and a couple of bits of dusty, barely relevant research unearthed from the forgotten archive of a medical museum.
The fact that those promoting this nonsense are allowed on YouTube and social media shows just how much they are supported and approved by the establishment.
Incidentally, some of those who don’t believe germs exist seem to base their belief on the fact that one or two specific viruses have not been identified. This doesn’t mean anything useful, of course. The fact that a specific virus hasn’t been identified doesn’t mean that there are no viruses or no germs – it merely means that the specific virus hasn’t been identified.
People have tried to bribe me to say publicly that there are no germs. They have threatened me physically and repeatedly abused me for stating my view that germs exist. I have asked the people who don’t believe in germs to accept that they believe one thing and I believe another. But they refuse to accept this. And it is relevant that many of the people who claim that germs do not exist have channels on YouTube and are allowed on all branches of social media. I am banned from YouTube and refused any access to Facebook, Twitter, LinkedIn, etc., but the no germ cultists are widely seen on these channels.
And that says it all, really, doesn’t it?
I do not intend to waste another minute on this piece of CIA-inspired buffoonery. Anyone who wants to believe that germs don’t exist is entitled to do so. But I bet they change their minds when they have a nasty bacterial infection that is causing great pain and threatening to kill them.
Meanwhile, consider this: if you wash your hands before eating or preparing food, then you believe in germs. If you wash a wound and use an antiseptic, then you believe in germs. If you or someone close to you has sepsis and thinks treatment might be wise, then you believe in germs. If you believe that sexually transmitted diseases exist, then you believe in germs.
If you don’t believe in germs, how do you explain the effectiveness of antibiotics, how do you explain Typhoid Mary and how do you explain how a single person with TB can infect a whole plane load of passengers with the disease? Of course germs exist!
I believe that the theory that germs don’t exist has been served up, garnished and devoured by innocents desperate to cling to any theory, however outlandish or unsubstantiated, which (understandably) encourages disapproval of the pharmaceutical industry and the medical establishment.
Most of those supporting the idea that germs don’t exist have never criticised the medical establishment or the drugs industry and have never dared poke their heads over the parapet. For over 50 years I have been the most vocal and most persistent critic of both, and that is why I am now so censored and demonised. Making up fake theories is of no value to anyone and it’s sad that those who have suddenly leapt on the idea that germs do not exist should use their platforms to attack me instead of attacking the real enemy.
And if you still don’t believe in germs, then that’s your right. But don’t expect sensible people to share your delusion.
I’m bored with this dangerous no-germ nonsense and tired of the arrogant ignorance and the deliberate abuse. The world is coming to an end and there are far more important things to discuss. I have no respect for anyone who believes that germs do not exist, and even less respect for anyone who promotes this insane hypothesis.
I do not intend to write any more on this subject because to do so would give credence to the dangerous nonsense which was, I believe, originally devised by bad actors and is now promoted by a few hundred cultists. If the cultists who don’t believe germs exist see this article, they will doubtless whinge, moan and threaten. And they’ll produce the usual see-through arguments with which they convince the ignorant and gullible who become their followers. It’s time for this delusion to end – it has done enormous damage to those of us fighting the establishment and it has, I suspect, been responsible for more than a few deaths. But I doubt if it will end just yet. Too many people are invested in what is no more than a cock and bull story to accept that they were wrong. Perhaps they need to study the influential work of Vladislav Surkov.
About the Author
Vernon Coleman, MB ChB DSc, practised medicine for ten years. He has been a full-time professional author for over 30 years. He is a novelist and campaigning writer and has written many non-fiction books. He has written over 100 books, which have been translated into 22 languages. On his website, HERE, there are hundreds of articles which are free to read. Since mid-December 2024, Dr Coleman has also been publishing articles on Substack; you can subscribe to and follow him on Substack HERE.
There are no ads, no fees and no requests for donations on Dr Coleman’s website or videos. He pays for everything through book sales. If you would like to help finance his work, please consider purchasing a book – there are over 100 books by Vernon Coleman available in print on Amazon.
The Expose Urgently Needs Your Help…
Can you please help to keep the lights on with The Expose’s honest, reliable, powerful and truthful journalism?
Your Government & Big Tech organisations
try to silence & shut down The Expose.
So we need your help to ensure
we can continue to bring you the
facts the mainstream refuses to.
The government does not fund us
to publish lies and propaganda on their
behalf like the Mainstream Media.
Instead, we rely solely on your support. So
please support us in our efforts to bring
you honest, reliable, investigative journalism
today. It’s secure, quick and easy.
Please choose your preferred method below to show your support.
Categories: Breaking News, World News
Mike yeadon doesn’t believe in viruses but he is not a kook. he worked for pharma for years and is a highly qualified scientist.
he’s been looking to debate someone about this for months, if not years.
perhaps you two should get together. he’s very heavily censored himself so i am not sure how this would work.
he does have a channel on telegram. the mike yeadon channel.
he’s thoughtful and kind and not at all bullying or dismissive.
i am a trained np in peds and psych. of course, my license was taken away for curing psych patients without using many of their drugs, which isn’t allowed.
having said that, i have done quite a bit of research and the virus question is one that’s open in my mind. i don’t really feel qualified to have an opinion yet bc i haven’t studied the issue deeply enough.
however, mr yeadon has been very thorough as far as i can tell, and such a debate would clarify my thinking, i am sure.
thank you for your voice. i will watch and see if you are able to arrange this.
Bacteria exist. Viruses not so much. The key question is do they cause disease.
Bacteria or viruses? I know virology (viruses) is false science-a lie, but I’m not sure what “bacteria” (a man-made label) is. I know what filth and poison is, and infections therefrom-these cause illness and death.
The answer is microzymas or somatids, bions, precursors – same thing on different names. They can be seen in the blood, they are everywhere, energy filled, intelligent tiny particles and they form bacteria and even fungi or cell(!) in us when the PH of the blood is changes.
Chapter 5 – Germs Are Not Our Enemy: Why the New Terrain Medicine Is Best for Optimal HealthVideo recording
https://www.youtube.com/watch?v=KGJW94ciq4c
I think we can believe in our own eyes…
The answer is microzymas or somatids, bions, precursors – same thing on different names. They can be seen in the blood, they are everywhere, energy filled, intelligent tiny particles and they form bacteria and even fungi or cell(!) in us when the PH of the blood is changes.
Chapter 5 – Germs Are Not Our Enemy: Why the New Terrain Medicine Is Best for Optimal Health
Video recording
https://www.youtube.com/watch?v=KGJW94ciq4c
I think we can believe in our own eyes…
Mike Yeadon is not a quack neither Dr Stefan Lanka neither some of the other scientists and doctors. there are also books like Virus Mania, or Can you catch a cold by Daniel Roytas etc. This has nothing to do with the CIA all to do with proper science. There is a lot of Scientific fraud happening when you look at the virus hypothesis. You mentioned about ear infection in children if you look at the data from vaxx versus unvaxx study there might be the explanation of this phenomena. etc etc.
Yeadon should go get out a bit more…
Dr Yeadon has been out protesting since the very beginning of the covid scamdemic. What were you doing? Staying at home wearing a muzzle and doing everything they told you to do?
Bacteria exist. Viruses not so much. The key question is do they cause disease.
So go bare back riding and find out they exist.
MMmmm…… so herbalists are kooks. So sound therapy is kooky. There is much evidence that tumours do decrease with sound therapy. There is much evidence that if we don’t take vaccines to destroy our immune system, then we should never contract anything that our body cannot deal with.
get back to the dirt so too speak lol vibration is fundamental , sunlight air water food don’t give up your cholesterol that’s your food of life as you get older dandelions nettle turmeric beef potatoes carrots vit K2 sun dried and so on remove the inflammation and the body will heal
Spacebusters video: ‘The End Of Germ THEORY’ explains it perfectly.
In Latin, the original meaning of ‘virus’ is TOXIN, POISON.
‘Viruses’ are EXOSOMES – dead cell debris, etc. that our bodies expel in the form of ‘cold’ or ‘flu’ symptoms when we have a toxic overload of a number of things – processed food/lack of nutrition, stress, EMF’s, chemtrail fallout, and lack of sunshine/Nature, lack of sleep and exercise…
Our bodies are miraculous self-healing organisms and the cells of our bodies continually ‘talk’ to each other – there is no such thing as ‘contagion.’
Virology is another LIE.
Bring on the debate!
And by the way, the world IS flat – plenty of proof (esp Biblical) out there for that as well.’
Kudos, finally someone with real-brain & upmost dignity admitted the TRUTH about this world (pangea) is FLAT. Thank you for not taking in the LIES by the ELITEs.
Check out the sun eclipse on August 2nd, 2027 covered half of the globe model will exposed 100% the lies of HELIOCENTRIC model.
And also, thank you for knowing the truth about poison/toxin of SMART-PROTEIN same as snake venom was mass produce by big pharma in VAX to poison & kill the masses slowly but surely die.
Simple observations of the moon destroys flat earth..simple observations of shadows thrown by the sun, especially in the southern hemisphere, prove heliocentricity. Sorry flerf. I’ve seen the 24 hour sun in Antarctica and the arctic…flerfers deny without proof. Get out of your mums basement, go to the ocean, hire a boat and go far far out on the ocean and then explain where the land went…and your prick 900 zoom won’t bring it back no matter how much you wail.
Reverend Scott I have a lot of respect for most of what you have expressed here and I am in agreement with a lot of your views, however I completely disagree with you on this one, and that’s okay.
When I first came across the ‘flat earth’ model not too long ago, I was like WTF?!!! But being relentlessly curious and an obsessive researcher, I dug deep…
May I suggest that you dig a little deeper and approach it with an open mind.
DustinNemos.com may help, also Bitchute and Rumble.There are stacks of resources out there.
All the best,
Nicole.
Pay NO attention to the ‘background’ noise. This person are been PAID to DISCREDIT all INDOCTRINATION narratives.
Anyone who lived on foundation of lies & deceit will always in judgement of karma. The different is, how soon the JUSTICE will be stamped on them.
Their lives will always be in scarcity & lack of monetary and love. Always lived on scraps of others & mercy of the death.
I was a structural and civil engineer and not once did I take into account any curvature. The equation used is miles squared times 8 inches for the supposed curvature of the Earth. I took a picture from Crosby in Southport to Blackpool, which is further up the coast. The straight line distance is 23 miles. According to the calculations that would be 4,232 inches or 352.66 feet. The Big One in Blackpool is 235 feet high, so with the mathematical equation used, the Big One would be hidden by the curvature. Not only did the picture show the Big One, it also showed the shops on ground level!
Sea level is not a myth, primary science proves that bodies of water will find their own level….Water does not curve….
And with you mentioning the Moon. Have you seen the Earth map that is imprinted on it’s surface?
The Earth is a flat realm Reverend, surrounded by a firmament. Space does not exist!…We are the centre of the universe, the Sun and Moon are local and rotate around our plane….
space the final frontier Give up your Money lol
Regarding “curvature”; was it not circa 1900 that Marconi successfully sent a radio signal across the Atlantic ocean-between the US & UK (some 3000 miles) this only being accomplished because the sea is level, hence the term sea level?
I couldn’t have said it better myself!
And thankyou for raising the topic of the moon (made of plasma) imprinted with the map of our FLAT earth! ; )
Thank YOU ARL, it’s always great to know that there are other like-minded real humans out there! ; ) and thankyou for your kind words of support.
Thanks also for the eclipse heads-up in Aug 2027…more of their lies exposed…YAY! Win!
Wishing you the very best : )
Nicole.
Paid trolls keeping the “conspiracy theorists” are all mad narrative alive..
https://www.youtube-nocookie.com/embed/ihsLPodE9R0 and does it ever work
-Coleman is consistently attacking the man, not the ball, the same way corporate media “fact checkers” do,
– implying his opponents are both KGB and CIA stooges, “nasty”, a “cult”, “enthusiastic bloggers”, “naïve, ignorant and misinformed”, not members of a harmless and slightly dotty group, but “dangerous”, “wild fervour” and a million other slurs.
-Flat earth is a bit like Goodwin’s law, the weaker the argument, the higher the likelihood of dragging out flat-earthers as a strawman,.
-When he claims “There is a subset cult whose members believe that viruses don’t exist, but most simply claim that there are no germs.” – my impression is directly the opposite, and I believe Coleman is claiming this on purpose in an attempt to misrepresent the “no virus”-proponents.
Coleman is also misrepresenting the majority of “no-bacteria”-proponents. Most “no bacteria” claim that the role of bacteria is misunderstood, and that they appear in already weakened tissue, i.e. as an effect, not a cause of illness.
I don’t think I have heard someone claim that bacteria don’t exist at all,
Exactly right!
FLAT EARTH is real deal. The problem s, masses was stuffed with FALSE flat earth floating in space. There are NO SPACE because we lived in closed ecosystem protected by celestial dome.
Just check the upcoming SUN ECLIPSE on 2nd. August 2027 to know the HELIOCENTRIC MODEL busted & exposed as legendary lies.
This is because the path of eclipse will covered HALF of the GLOBE model and at the same time GLOBE suddenly not spinning & moving in order to make sense the path was able to travel from WEST to EAST more than 6 hours.
Human with brain & conscience should see & start ASKING the question to NASA & other space agency…. HOW WILL YOU TWIST THIS TRUTH of HELIOCENTRIC LIES…???!!!
For sure the Pasteur V Béchamp debate will continue.
The real issue is to allow real science to develop what is unfinished business.
Germ theory is not the whole answer.It requires questioning open minds void of medical indoctrination.
It was only through the likes of Galileo that a flat world became accepted as round, who also was accused of being delusional.There are many in the medical profession that believe in Pasteur, however with the advent of “real” science, and those that question the established narrative, the truth still needs to be evidenced either way.Currently it is only in part resolved.
I now have multiple other possibilities to consider not least RNA particulates that piggyback wayward exosomes.
James Hildreth John Hopkins University work on Aids, and Human retrovirus HIV using the Trojan Horse of exosomes.
When is a virus an exosome?
As to all hypotheses they need to also be considered, not denigrated or ridiculed.
Real science is about considering all possibilities and using “real” evidence to make a conclusion.
Today’s society is far to indoctrinated to consider anything but the medical one-story narrative. Much like the Covid years.
As to peer reviewed research evidence that disappeared long ago as corrupted, conflict of interest, or financed by BigPharma.
What remains is people have to research their own evidence and make their own minds up.
I leave you with my own;
Germ Theory Isn’t the Whole Answerhttps://johnblundell.substack.com/p/why-germ-theory-isnt-the-whole-answer?r=3fft71
GERM do exist because we could see it with microscope.
VIRUS, 100% not exist because, Electron Microscope was a shady invention allegedly could ‘shot’ BLACK & WHITE photo of extremely-small area smaller than a dot was real deal to prove bigger area was infested by virus. And, yet proven, scientists still FAILED to isolate the pathogen successfully.
WARNING to people of INDIA right now. Because more than 80% of the population do NOT take the vax earlier. The population growth was ranked 1st in the world. This is a real danger & threat to the CULLING AGENDA. Useless eater need to to killed.
Right now, scare tactic of NIPAH VIRUS outbreak was propagandized to push the vaccination program in order to eliminate the rest of the rest of 80% UN-VAXXED India’s population.
Seems Dr Vernon is being a hypocrites. Attacking people who have looked into virology and discovered just how they ‘isolate’ them. They don’t. They culture something, but not viruses.. they also fail kochs postulate…and then he goes on to gaslight them by referring to ‘germs’. One or the other Doc…he even exposes himself with the antibiotics stuff…they don’t work on colds or flu do they? Colds and flu are allegedly caused by ‘viruses’….too much sherry when you wrote this diatribe eh Doc.. MoD trained chemist by the way.. oil isn’t fossil by the way, and its not running out…and never will….its more profitable if its considered scarce…hydrogen and Carbon…not scarce…just endlessly recycled…
Right on!
For all those that don’t believe in viruses go bare back riding in Phillipines or Thailand for a few weeks and report back.
Before I went to that first joint (no bare back riding though lol, I was on some motorped thing), someone talked me into getting an injection (hopefully I wouldn’t do it these days) for about 4 different ‘scary diseases’. I went right out into the jungle to someone’s wooden hut. A bit rustic but that family was living fine.
Although there are some little microscopic critters of some description that can be helpful or harmful, depending on the situation.
Glad your post made sense to you.
Germs do exist but proving viruses exist is a very tough nut to crack given that most laboratories refuse to use standard Koch postulates to prove such a pathogen is real. Most viruses today are claimed to be real under the assumption of a computer AI, which does nothing more than support those who paid for the insilico results.
If a laboratory cannot prove they’ve isolated a pathogen and can force it to multiply then test it against infecting other sources, it just a game of words.
If this really was “the truth about germs” then my detailed response to this article would not keep disappearing. The truth can withstand scrutiny. Lies and untruths have to be protected with censorship.
Your “detailed response” is nearly 800 words long, i.e., article length and not comment length – that’s why it keeps disappearing.
You’ve been commenting on this site for long enough to know that we consider comments to be less than about 200 words, and comments longer than that “disappear” as you put it.
Then why not post it as an article then? As you well know i wrote many articles for The Expose prior to you apparently taking over full editorial control. The truth will out so be on the right side of history.
Sam, you say, “Then why not post it as an article then?” No. And there’s no point asking the question again because the answer will always be “no.”
You know as well as I do how you’ve conducted yourself on this site over the years and why I have good reason to be suspicious of you, your motives and who you’re acting on behalf of.
It was another well written post Sam, that I managed to read before it ‘disappeared’….
Funnily enough, I’ve seen plenty of posts on here, that have been longer than the article itself….So I actually think it’s selective with what actually ‘disappears’.
My comments also keeps disappearing under pretext justification of ‘too long’ or ‘suddenly just vanished’ without warning or notification.
She may have her own “reason” to keep the ‘TRUTH’ from spreading.
My comments was all screen video recording for future proof.
AkashicRecordLibrarian, perhaps I need to lay out the basic rules of commenting on this website. Long comments will be blocked or deleted, as will abusive, racist or troll-like comments. Do any of your comments that “disappeared” fit into those categories?
In other words, stay respectful and debate a topic rather than engage in “attacking” people. To help you gauge for yourself what is appropriate, i.e. monitor your comments for yourself: Pretend you were at a coffee shop having a chat – what would you or would you not say to your coffee mate in public that you know everyone, including the shop owner, can overhear?
The term “germ” used by Vernon is too imprecise even vague. There is no debate that there are infectious bacteria that can be spread. There are also parasites. Both these “germs” can be seen under a microscope. It is the class of “viruses” that are not seen in vivo under microscopes whose existence is contested. Not all germs. Viruses have never been seen live only inferred by biochemical processes. They have also never actually been shown to directly cause any disease whatsoever. It is always by inference. So Dr. Coleman misconstrues the debate which has been going on since the 19th C. fight between Bertrand and Pasteur. Bertrand believed that the inner terrain was the source of disease whereas Pasteur held to the germ theory where disease was caused by external organisms ie. germs. The germ theory won out, but in his diary just before he died Pasteur admitted that “the terrain was everything”.
Now this is what I call a comment! As I was reading Dr. Coleman’s post, I could not help but notice his slurs against others, something he does not appreciate being on the receiving end of himself yet has no problem dishing it out. Some of his remarks concerning certain individuals wanting to “kill him” for disagreeing with them, sound outrageous, if however they are accurate, I suggest Dr. Coleman take this matter up with the Police Dept in his area Not that this would accomplish anything but at least they would have his statement concerning this threat to his life. It actually sounds like he is doing his utmost to discredit the work of others when he has done none whatsoever himself. As for debates, there are plenty of well known individuals out there who are more than willing to discuss the situation we find ourselves in, but have had little success in finding anyone from the mainstream medical establishment to which Dr. Coleman surely belongs, even though he would have us believe otherwise. And for the record Dr. Coleman, “Covid ” was not the rebranded flu as you would so love for us to believe. It was nothing! To say that it was the rebranded flu is giving credence to their lying narrative that it was a “health event ” It was no such thing! What occurred in 2020 was their decades long planned takeover, which many are still utterly oblivious to. It was so very frustrating in the early days of fake Covid to hear him ramble on with this line when it was known by many what was really taking place. For this reason alone, I could never really listen to him. I tried but he continually spoke of “the flu ” Because of his ignorance he cannot be taken seriously but can very much cause damage to new-found truths that have been hidden from mankind. Again, best comment on this fiasco.
Earth is flat!!
Viruses don’t exist!
Paid trolls doing the work of government to keep the “conspiracy theorists are nut jobs” narrative alive.
That way peeps dimiss eveything as a conspiracy theory like the efficacy of the Covid jab or that Covid was a killer virus..
You are definitely a troll. Does it pay well or do you do it for free because misanthropy gives you a buzz?
Well, I think he may be paid because someone with that first and last name does videos where he has to have allegiance to Alex Jones, I think, (but we can assume it’s someone else if we wish to as it’s a common name) so might not be as free to talk as those with no paid allegiances but sometimes the P.W. videos I’ve seen (like one on climate change ‘scam’ once) can be quite good!
There are some highly qualified physicians who argue that no viruses have been isolated and purified, and therefore not a single virus has been proven to exist. The pictures they claim are viruses are indistinguishable from dead cell debris. When the body detoxifies dead cell debris, it can make you feel sick and lousy like having a flu.
Three doctors, including Samantha Bailey authored a book “Virus Mania “, which exposes and explains this in depth and very well referenced. I highly recommend reading this book to understand this topic.
The Virology Controls Studies Project led by Jamie Andrews have gone a step further. They are sending samples that cannot possibly contain any virus to contract labs. These samples generate cytopathic effects in cell cultures, EM shows particles the labs call “viruses”, and they have constructed “viral” genomes on their computers from these samples. They have expanded on the practical work that Dr Stefan Lanka started. Virology has been completely debunked experimentally and not just theoretically. Anybody not paying attention is being wilfully ignorant.
Perfectly stated. Thank you for your hard work. The truth will set us free.
Thanks but its Jamie and his group that are doing the hard work. If you are not familiar with him you should look him up. Very smart and also very funny. He is also completely debunking genetics. I spent a lot of my career doing genetics and virology. Jamie is right and if i can admit that then others like Dr Coleman should also be able to admit it. As you rightly say the truth will set us free.
No calling names at viroliegy.com How come?
https://cms.viroliegy.com/2026/01/25/reality-of-illness/
Mike Stone has never removed an appendix or treated an ear infection and so his views don’t count! Yes he does write detailed articles fully sourced directly from the virology literature but he is still a crazy ignorant cult member in Dr Coleman’s world.
Wow, I didNt know that there are people out there, who doNt believe that germs exist..❕😲 Once again, very good article from U Mr V. Coleman..❕🥰🥰